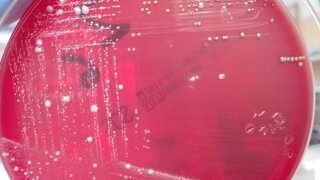
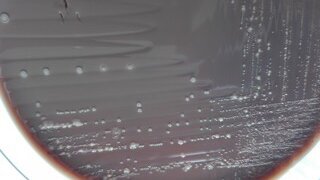

-
 Austria / Österreich
Austria / Österreich
-
 Bośnia i Hercegowina / Босна и Херцеговина
Bośnia i Hercegowina / Босна и Херцеговина
-
 Bułgaria / България
Bułgaria / България
-
 Chorwacja / Hrvatska
Chorwacja / Hrvatska
-
 Czechy i Słowacja / Česká republika & Slovensko
Czechy i Słowacja / Česká republika & Slovensko
-
 Francja / France
Francja / France
-
 Niemcy / Deutschland
Niemcy / Deutschland
-
 Grecja / ΕΛΛΑΔΑ
Grecja / ΕΛΛΑΔΑ
-
 Węgry / Hungary
Węgry / Hungary
-
 Włochy / Italia
Włochy / Italia
-
 Holandia / Nederland
Holandia / Nederland
-
 nordycki / Nordic
nordycki / Nordic
-
 Polska / Polska
Polska / Polska
-
 Portugalia / Portugal
Portugalia / Portugal
-
 Rumunia i Mołdawia / România & Moldova
Rumunia i Mołdawia / România & Moldova
-
 Słowenia / Slovenija
Słowenia / Slovenija
-
 Serbia i Czarnogóra / Србија и Црна Гора
Serbia i Czarnogóra / Србија и Црна Гора
-
 Hiszpania / España
Hiszpania / España
-
 Szwajcaria / Schweiz
Szwajcaria / Schweiz
-
 indyk / Türkiye
indyk / Türkiye
-
 Wielka Brytania i Irlandia / UK & Ireland
Wielka Brytania i Irlandia / UK & Ireland
 Międzynarodowy / International
Międzynarodowy / International
 Brazylia / Brasil
Brazylia / Brasil
 Kanada / Canada
Kanada / Canada
 Ameryka Łacińska / Latinoamérica
Ameryka Łacińska / Latinoamérica
 USA / USA
USA / USA
 Chiny / 中国
Chiny / 中国
 Indie / भारत गणराज्य
Indie / भारत गणराज्य
 Pakistan / Pākistān
Pakistan / Pākistān
 Wietnam / Việt Nam
Wietnam / Việt Nam
 ASEAN / ASEAN
ASEAN / ASEAN
 Izrael / מְדִינַת יִשְׂרָאֵל
Izrael / מְדִינַת יִשְׂרָאֵל
 Algieria, Maroko i Tunezja / الجزائر والمغرب وتونس
Algieria, Maroko i Tunezja / الجزائر والمغرب وتونس
 Bliski Wschód / Middle East
Bliski Wschód / Middle East